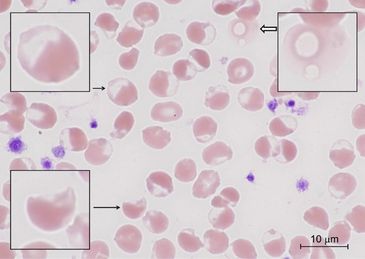

My experience was with my sickle cell trait gene
Rhabdomyolysis durin Boot Camp.
Asking Soldiers about Rhabdomyolysis
“Trainers”
What is Rhabdomyolysis?
Rhabdomyolysis is a condition characterized by the breakdown of muscle tissue, leading to the release of muscle fibers into the bloodstream. This can cause severe complications, including acute kidney injury (AKI) and electrolyte imbalances.
What is Sickle Cell Trait (SCT)?Sickle Cell Trait (SCT) is a genetic condition where an individual inherits one sickle cell gene (HbS) from one parent and a normal hemoglobin gene (HbA) from the other. While SCT is generally considered a benign condition, certain stressors can trigger complications, including rhabdomyolysis.
Rhabdomyolysis is a condition characterized by the rapid breakdown of skeletal muscle tissue, causing muscle breakdown products to leak into the bloodstream. One such product, the protein myoglobin, can be particularly harmful to the kidneys, potentially leading to acute kidney injury. The severity of rhabdomyolysis varies, from asymptomatic increases in muscle enzymes in the blood to severe, life-threatening conditions involving extreme enzyme elevations, electrolyte imbalances, and kidney damage..
Connection Between SCT and Rhabdomyolysis:
Individuals with SCT are at increased risk of rhabdomyolysis under specific conditions such as extreme physical exertion, dehydration, or high temperatures. The sickling of red blood cells can lead to microvascular occlusions, reduced blood flow, and subsequent muscle damage.
Increased Risk of Rhabdomyolysis in Individuals with SCT
Understanding the Connection: Explain how the presence of the HbS gene in individuals with SCT can lead to increased susceptibility to rhabdomyolysis under certain conditions. Highlight that while SCT is generally considered benign, specific stressors such as intense physical exertion, dehydration, and high temperatures can cause red blood cells to sickle. This sickling can lead to blockages in blood vessels, reducing blood flow and oxygen to muscles, which can result in muscle breakdown and rhabdomyolysis.
Recognition and Early Intervention to Prevent Severe Complications
Symptoms and Warning Signs:** Emphasize the importance of recognizing early symptoms of rhabdomyolysis in individuals with SCT, including severe muscle pain, weakness, swelling, dark urine, and general fatigue. Educate the audience on the need for immediate medical attention if these symptoms occur.
Inherited Genes Associated with Rhabdomyolysis
Dr O addresses my Rhabdomyolysis experience with research information.
https://www.health.mil/News/Articles/2022/04/01/EX-RHAB-MSMR





People all over the Globe from working out in the gym, to doing CrossFit, to Military Solider have experienced and died from Rhabdomyolysis.
Rhabdomyolysis is a skeletal muscular disorder that can be triggered by inherited gene, medication, dehydration and more
Rhabdomyolysis can affect many parts of the body. Swelling in limbs, Severe Muscle Fatigue, and Renal Failure which can lead to dialysis to name a few.
There are hundreds of other types of red blood cell conditions and blood disorders like Sickle Beta Thalassemia, Sickle Cell SC , Sickle Cell SD, SE and many more.
The muscle breakdown is measured by the Creatine Kinase Levels aka CK or CPK.
Rhabdomyolysis aka Rhabdo aka Exertinal Sickling with Rhabdo
Rhabdomyolysis (Rhabdo) occurs when muscle fibers break down and release their contents, including proteins like myoglobin, into the bloodstream. This can lead to kidney damage and other complications. When severe, it can impact the heart’s electrical system and overall function.
Regarding negative electrical charge and the heart, the heart relies on electrical impulses to maintain a regular rhythm. These impulses are generated by ions (charged particles like sodium, potassium, calcium) moving in and out of heart cells, which creates the electrical signals needed for contraction. If something disrupts these ion balances, such as in severe rhabdomyolysis, it can cause abnormal heart rhythms (arrhythmias), which may lead to the heart stopping (cardiac arrest).
Several factors can contribute to the heart stopping during severe rhabdomyolysis:
1. Electrolyte Imbalance: The breakdown of muscle cells releases potassium into the bloodstream, leading to hyperkalemia (excessive potassium), which can cause life-threatening arrhythmias.
2. Acidosis: Muscle breakdown can lead to a buildup of acid in the blood (metabolic acidosis), which also disrupts normal heart function.
3. Dehydration and Hypovolemia: Loss of fluids from muscle breakdown can reduce blood volume, lowering blood pressure, and depriving the heart of enough oxygen to function properly.
4. Kidney Failure: Myoglobin released from damaged muscles can clog the kidneys, leading to acute kidney failure, which in turn worsens electrolyte imbalances, affecting the heart.

How important is hydration to you?
Sickle Cell Trait / Rhabdomyolysis can make people sick if they do too much exercise without drinking enough water or warming up. It can hurt their muscles and kidneys. It's important to get help if this happens, and to drink lots of water and start slowly when exercising. Coaches should also be careful.
Rhabdomyolysis talks.
Rhabdomyolysis and the Heart
What I found in medical community
Speaking at every opportunity to bring awareness to this global conversation and risk factors that can cause sudden death.
Driving into radio class and doing my assignment I heard them talking so I called in.
Driving into radio class and doing my assignment I heard them talking so I called in.
Driving into radio class and doing my assignment I heard them talking so I called in.

Rhabdomyolysis
Who can get rhabdo?
Anyone can get rhabdo, but some workers are at a higher risk than others. People who work in hot environments and/or perform strenuous physical tasks have a higher chance of getting rhabdo. Some of these groups include:
Rhabdomyolysis
Who can get rhabdo?
Anyone can get rhabdo, but some workers are at a higher risk than others. People who work in hot environments and/or perform strenuous physical tasks have a higher chance of getting rhabdo. Some of these groups include:

Anyone can experience Rhabdomyolysis

Just a few symptoms of rhabdomyolysis. I did not have the dark color urine. My S Trait was apart of the issue.
Schedule a call with me:
https://calendly.com/farrondozier/60min

Two potential conditions: rhabdomyolysis and fat embolism syndrome (FES). Both can be connected, but they are distinct conditions with different causes and effects.
Rhabdomyolysis
• What It Is: Rhabdomyolysis is a condition where there is a rapid breakdown of muscle tissue, releasing muscle fiber contents (such as myoglobin) into the blood
Two potential conditions: rhabdomyolysis and fat embolism syndrome (FES). Both can be connected, but they are distinct conditions with different causes and effects.
Rhabdomyolysis
• What It Is: Rhabdomyolysis is a condition where there is a rapid breakdown of muscle tissue, releasing muscle fiber contents (such as myoglobin) into the bloodstream. This can occur due to extreme physical exertion, trauma, or certain medical conditions, and can lead to kidney damage.
• Connection to Sickle Cell Trait (SCT): In people with SCT, exertional sickling can cause muscle breakdown, leading to rhabdomyolysis. The release of myoglobin and other muscle cell contents into the bloodstream can overwhelm the kidneys, leading to kidney damage or failure.
Fat Embolism Syndrome (FES)
• What It Is: FES occurs when fat droplets enter the bloodstream, often after trauma or injury to bone or fat tissue. These droplets can travel to the lungs, kidneys, brain, and other organs, causing blockages and leading to symptoms like respiratory distress, neurological symptoms, and organ failure.
• Connection to SCT and Rhabdomyolysis: In the context of SCT and rhabdomyolysis, muscle breakdown might lead to the release of fat droplets into the bloodstream, potentially resulting in FES. However, FES can also occur independently from rhabdomyolysis if fat is introduced into the bloodstream through other means (like bone fractures or certain surgeries).
Key Distinctions
• Rhabdomyolysis is the breakdown of muscle tissue, which can lead to kidney damage due to the release of muscle contents like myoglobin into the bloodstream.
• FES is the blockage of blood vessels by fat droplets, which can occur as a secondary complication of rhabdomyolysis or other injuries.
In your situation, the individual may have experienced rhabdomyolysis due to exertional sickling, and this breakdown of muscle tissue could have led to fat embolism syndrome, which ultimately caused severe complications like kidney failure, lung issues, and cardiac arrest.
So, it’s possible the person experienced both conditions: rhabdomyolysis as a result of sickling, which then contributed to fat embolism syndrome (FES).

It can be particularly dangerous due to the combined effects of the two conditions. Here’s a breakdown of what happens:
Fat Embolism Syndrome (FES) Overview
• FES occurs when fat droplets enter the bloodstream and block blood vessels in vital organs like the lungs, brain, and kidneys. It’s often associated with trauma, such as fractures of
It can be particularly dangerous due to the combined effects of the two conditions. Here’s a breakdown of what happens:
Fat Embolism Syndrome (FES) Overview
• FES occurs when fat droplets enter the bloodstream and block blood vessels in vital organs like the lungs, brain, and kidneys. It’s often associated with trauma, such as fractures of long bones, but can also occur due to other factors like severe inflammation, surgery, or, in rare cases, the breakdown of fat tissue in conditions like rhabdomyolysis.
Sickle Cell Trait (SCT) and Its Complications
• Sickle Cell Trait is generally a benign condition, but under extreme physical stress, dehydration, or low oxygen levels, the red blood cells can “sickle” or change shape. This can cause blockages in small blood vessels, leading to complications such as pain, organ damage, or exertional rhabdomyolysis.
When FES and SCT Occur Together
• Exertional Sickling: In a person with SCT, extreme physical exertion can trigger sickling of red blood cells. This sickling can cause muscle breakdown (rhabdomyolysis), releasing fat into the bloodstream.
• Rhabdomyolysis Leading to FES: The muscle breakdown from rhabdomyolysis releases intracellular contents, including fat, into the bloodstream. These fat droplets can travel to the lungs, kidneys, and other organs, causing blockages that characterize FES.
Effects of FES in SCT
1. Respiratory Distress: Fat droplets can block blood vessels in the lungs, leading to severe respiratory issues like shortness of breath, low oxygen levels, and potentially acute respiratory distress syndrome (ARDS).
2. Kidney Damage: The fat emboli can obstruct blood flow to the kidneys, leading to acute kidney injury. This can be exacerbated by the myoglobin released during rhabdomyolysis, which can further damage the kidneys.
3. Cardiac Complications: The combination of respiratory distress, kidney failure, and the overall strain on the body can lead to cardiac arrest, as the heart struggles to maintain adequate oxygen delivery to vital organs.
4. Neurological Symptoms: If fat droplets reach the brain, they can cause confusion, altered consciousness, or even seizures due to the blockage of cerebral blood vessels.
Clinical Presentation
• Timing: FES usually develops 24 to 72 hours after the initial injury or stressor.
• Symptoms: Early symptoms include shortness of breath, low oxygen levels, rapid breathing, and confusion. This can quickly progress to severe respiratory failure, kidney failure, and multi-organ dysfunction.
Why It’s Dangerous in SCT
• In SCT, the sickling of red blood cells under stress can complicate FES by further blocking blood flow in small vessels, exacerbating the organ damage caused by fat emboli. The dual impact on the lungs, kidneys, and other organs makes it a life-threatening situation that requires immediate medical intervention.
Management and Treatment
• Early Detection: Identifying FES early is critical, especially in individuals with SCT who are at higher risk under conditions of physical stress.
• Supportive Care: Treatment typically involves respiratory support, maintaining adequate oxygen levels, and managing any complications in the kidneys, heart, and other organs.
• Hydration and Oxygen: Preventing exertional sickling by ensuring proper hydration and oxygenation during physical activity is vital for those with SCT.
In summary, the combination of FES and SCT creates a severe and complex medical emergency, with the potential for rapid deterioration. Immediate medical care is essential to manage the symptoms and prevent fatal outcomes.

Rhabdomyolysis can be triggered by various factors, even in the absence of red blood cell disorders like Sickle Cell Trait. Cold exposure and certain white blood cell (WBC) conditions can also contribute to the development of rhabdomyolysis. Here’s how they can play a role:
How Cold Exposure Can Trigger Rhabdomyolysis
Even without a red blo
Rhabdomyolysis can be triggered by various factors, even in the absence of red blood cell disorders like Sickle Cell Trait. Cold exposure and certain white blood cell (WBC) conditions can also contribute to the development of rhabdomyolysis. Here’s how they can play a role:
How Cold Exposure Can Trigger Rhabdomyolysis
Even without a red blood cell condition, cold temperatures can lead to muscle breakdown in several ways:
1. Hypothermia:
• Prolonged exposure to cold can cause the body’s core temperature to drop, leading to hypothermia. This affects muscle function and blood flow, causing muscle cells to break down, which can trigger rhabdomyolysis.
• Muscle shivering, which occurs as the body tries to generate heat, can also lead to muscle damage and breakdown if sustained for long periods.
2. Cold-Induced Vasoconstriction:
• Cold exposure can cause blood vessels to constrict (vasoconstriction), reducing blood flow to muscles and depriving them of oxygen. This oxygen deprivation can lead to muscle injury, contributing to rhabdomyolysis.
3. Cold Water Immersion:
• Immersion in cold water (such as during cold-water swimming) can result in both hypothermia and muscle damage due to extreme exertion combined with cold-induced vasoconstriction. This is especially common in endurance sports or military training.
White Blood Cell (WBC) Conditions That Can Trigger Rhabdomyolysis
Certain white blood cell (WBC) conditions can also lead to rhabdomyolysis, even causing extremely high creatine kinase (CK) levels (like 100,000 U/L or more). One such condition is hemophagocytic lymphohistiocytosis (HLH).
1. Hemophagocytic Lymphohistiocytosis (HLH):
• What It Is: HLH is a life-threatening condition in which the immune system becomes overly activated, leading to widespread inflammation. It involves an uncontrolled activation of white blood cells (mainly histiocytes and lymphocytes) that start attacking the body’s own tissues.
• Rhabdomyolysis Connection: HLH can cause severe inflammation, which may lead to muscle damage and subsequent rhabdomyolysis. In HLH, rhabdomyolysis might develop as a secondary complication due to the intense immune activation and inflammatory damage to muscles.
• Creatine Kinase Levels: CK levels can skyrocket during rhabdomyolysis, with values exceeding 100,000 U/L in extreme cases. Inflammatory conditions like HLH can exacerbate muscle damage, leading to such high CK levels.
2. Severe Infections or Sepsis:
• What It Is: Certain infections, especially those that lead to sepsis, can cause widespread inflammation and immune activation, which may damage muscle tissue. White blood cells release cytokines and other inflammatory molecules, which can contribute to muscle injury and rhabdomyolysis.
• Rhabdomyolysis Connection: Infections like viral myositis or bacterial sepsis can cause muscle inflammation and breakdown. Some infections, like influenza, can lead to viral myositis, which can trigger rhabdomyolysis even in the absence of a genetic red blood cell condition.
• Creatine Kinase Levels: Severe cases of infection-induced rhabdomyolysis can cause extremely high CK levels, often as part of a multi-organ failure in sepsis.
3. Leukemia (Acute or Chronic):
• What It Is: Leukemia is a cancer of the white blood cells. Some forms of leukemia, especially during the initial presentation or during treatment (e.g., tumor lysis syndrome), can cause muscle breakdown.
• Rhabdomyolysis Connection: In some cases, leukemia can lead to metabolic complications, including rhabdomyolysis. Additionally, if leukemia infiltrates muscle tissue, it can cause direct muscle damage.
• Creatine Kinase Levels: CK levels can become elevated if rhabdomyolysis develops as a secondary complication in leukemia.
4. Autoimmune Diseases (e.g., Polymyositis or Dermatomyositis):
• What They Are: Autoimmune diseases like polymyositis and dermatomyositis are conditions where the immune system mistakenly attacks muscle tissue. These conditions are characterized by chronic muscle inflammation.
• Rhabdomyolysis Connection: In cases of severe or untreated polymyositis or dermatomyositis, the ongoing inflammation can lead to extensive muscle damage and rhabdomyolysis.
• Creatine Kinase Levels: CK levels can become extremely high due to the ongoing muscle inflammation in these conditions, sometimes exceeding 100,000 U/L in severe cases.
Key Takeaways:
Cold Exposure: Rhabdomyolysis can occur in response to cold exposure due to hypothermia, prolonged shivering, or cold-induced vasoconstriction.
White Blood Cell Conditions: Conditions like HLH, severe infections, certain leukemias, and autoimmune diseases can all lead to rhabdomyolysis due to excessive inflammation or direct muscle damage.
High CK Levels (100K+): Conditions that trigger severe rhabdomyolysis, such as infections, autoimmune diseases, or HLH, can cause creatine kinase (CK) levels to exceed 100,000 U/L, indicating extensive muscle damage.

Red Blood Cell (RBC) Disorders That Can Cause Rhabdomyolysis
1. Sickle Cell Disease (SCD) and Sickle Cell Trait (SCT)
• Description: Sickle cell disease is a genetic disorder where red blood cells become abnormally shaped (sickle-shaped), leading to blockages in blood vessels, reduced oxygen delivery to tissues, and increased risk of musc
Red Blood Cell (RBC) Disorders That Can Cause Rhabdomyolysis
1. Sickle Cell Disease (SCD) and Sickle Cell Trait (SCT)
• Description: Sickle cell disease is a genetic disorder where red blood cells become abnormally shaped (sickle-shaped), leading to blockages in blood vessels, reduced oxygen delivery to tissues, and increased risk of muscle damage. Sickle cell trait is a milder form where only one sickle cell gene is present, but muscle breakdown can still occur under stress.
• Triggers: Dehydration, intense physical exertion, high altitudes, low oxygen levels, and extreme temperatures can trigger sickling in the red blood cells, leading to rhabdomyolysis.
2. Glucose-6-Phosphate Dehydrogenase (G6PD) Deficiency
• Description: G6PD deficiency is a genetic disorder where red blood cells are more susceptible to oxidative stress, leading to their breakdown (hemolysis) under certain conditions. This can result in decreased oxygen supply to muscles, contributing to muscle damage and rhabdomyolysis.
• Triggers: Infections, certain medications (e.g., antimalarials, sulfa drugs), and consumption of fava beans can lead to oxidative stress, triggering hemolysis and, in severe cases, rhabdomyolysis.
3. Autoimmune Hemolytic Anemia (AIHA)
• Description: AIHA is a condition where the immune system mistakenly attacks and destroys red blood cells, causing hemolysis. The resulting anemia can lead to muscle ischemia (reduced blood flow to muscles), increasing the risk of rhabdomyolysis.
• Triggers: Infections, medications, and autoimmune diseases can trigger AIHA and its associated complications.
4. Paroxysmal Nocturnal Hemoglobinuria (PNH)
• Description: PNH is a rare, life-threatening blood disorder where red blood cells break apart (hemolysis) due to a genetic mutation affecting the surface proteins of red blood cells. This destruction can result in poor oxygen delivery to muscles and contribute to muscle damage.
• Triggers: Physical exertion, infections, and certain medications can trigger hemolysis and subsequent muscle damage in PNH patients.
White Blood Cell (WBC) Disorders That Can Cause Rhabdomyolysis
1. Hemophagocytic Lymphohistiocytosis (HLH)
• Description: HLH is a rare, life-threatening condition where the immune system becomes overactive, leading to widespread inflammation and tissue damage, including muscle damage and rhabdomyolysis. It involves the excessive activation of certain white blood cells (histiocytes and lymphocytes) that start attacking healthy tissue.
• Triggers: Viral infections, genetic mutations, and autoimmune disorders can trigger HLH. The intense inflammation can cause muscle breakdown and rhabdomyolysis.
2. Leukemia (Acute or Chronic)
• Description: Leukemia is a type of cancer that affects white blood cells, causing them to proliferate abnormally. In some cases, the disease or its treatment (e.g., chemotherapy) can cause muscle breakdown, leading to rhabdomyolysis.
• Triggers: Chemotherapy, infections, or tumor lysis syndrome (where cancer cells break down rapidly and release harmful substances) can trigger rhabdomyolysis in leukemia patients.
3. Systemic Lupus Erythematosus (SLE)
• Description: SLE is an autoimmune disease where the immune system attacks multiple organs, including the muscles. This chronic inflammation can lead to muscle damage (myositis), resulting in rhabdomyolysis.
• Triggers: Infections, stress, and certain medications can trigger lupus flares, leading to inflammation and rhabdomyolysis.
4. Polymyositis/Dermatomyositis
• Description: These are autoimmune diseases that cause chronic inflammation of the muscles (myositis). The ongoing muscle damage can lead to rhabdomyolysis, especially during disease flare-ups.
• Triggers: Infections, physical exertion, and certain medications can exacerbate these conditions, causing rhabdomyolysis.
5. Infections Leading to Sepsis (Sepsis-Induced Rhabdomyolysis)
• Description: Severe infections, especially those leading to sepsis, can cause widespread inflammation, involving white blood cells that release cytokines and other inflammatory mediators. This can lead to muscle breakdown and rhabdomyolysis.
• Triggers: Bacterial, viral, or fungal infections that progress to sepsis can cause the body to mount an exaggerated immune response, resulting in rhabdomyolysis.
Summary of Triggers and Mechanisms
• Red Blood Cell Disorders: These conditions often involve poor oxygen delivery to muscles, which can lead to muscle breakdown under physical stress, infections, or low oxygen conditions.
• White Blood Cell Disorders: These conditions typically involve an overactive immune response or inflammation, which can cause muscle damage, especially during flare-ups, infections, or treatment with certain drugs.
Each of these conditions affects muscle integrity through either oxygen deprivation (RBC-related) or immune-mediated inflammation (WBC-related), both of which can trigger rhabdomyolysis under the right circumstances.
Glucose-6-Phosphate Dehydrogenase (G6PD) deficiency and rhabdomyolysis can intersect in specific ways, though G6PD deficiency primarily affects red blood cells. Here’s how G6PD deficiency can contribute to rhabdomyolysis and how it typically expresses itself:
G6PD Deficiency Overview
• What is it? G6PD deficiency is a genetic condition whe
Glucose-6-Phosphate Dehydrogenase (G6PD) deficiency and rhabdomyolysis can intersect in specific ways, though G6PD deficiency primarily affects red blood cells. Here’s how G6PD deficiency can contribute to rhabdomyolysis and how it typically expresses itself:
G6PD Deficiency Overview
• What is it? G6PD deficiency is a genetic condition where red blood cells lack enough of the G6PD enzyme, which protects the cells from oxidative stress. Without adequate G6PD, red blood cells are more vulnerable to damage and breakdown (hemolysis) when exposed to certain triggers.
• Primary Symptoms: In most cases, G6PD deficiency manifests through episodes of hemolytic anemia, particularly after exposure to triggers like certain foods (e.g., fava beans), medications (e.g., sulfa drugs), or infections. Symptoms can include jaundice, dark urine, fatigue, and shortness of breath.
How G6PD Deficiency Can Contribute to Rhabdomyolysis
1. Oxidative Stress and Muscle Damage:
• In G6PD deficiency, the body is less capable of neutralizing oxidative stress. When cells are exposed to oxidative substances, red blood cells undergo hemolysis, and muscle cells may also suffer damage.
• Severe oxidative stress from infections, certain medications, or strenuous exercise can overwhelm the muscle cells (myocytes), causing them to break down. This can lead to the release of muscle proteins like myoglobin into the bloodstream, a hallmark of rhabdomyolysis.
2. Hemolysis-Related Muscle Ischemia:
• During hemolytic episodes (common in G6PD deficiency), the body experiences a drop in red blood cells and hemoglobin, reducing the oxygen supply to muscles. This oxygen deprivation (ischemia) in muscles can lead to muscle damage and rhabdomyolysis, especially under stressful conditions such as infection, fever, or physical exertion.
3. Infection-Triggered Rhabdomyolysis:
• Infections are a well-known trigger for hemolysis in G6PD deficiency, but they can also induce rhabdomyolysis. Infections cause widespread inflammation and oxidative stress, affecting both red blood cells and muscle tissue. In individuals with G6PD deficiency, the lack of oxidative protection can amplify this stress, leading to both hemolysis and rhabdomyolysis.
• Viral infections, in particular, can cause both myositis (inflammation of muscle tissue) and hemolysis, creating a perfect storm for muscle breakdown and rhabdomyolysis.
How G6PD Deficiency and Rhabdomyolysis Express Themselves Together
When G6PD deficiency and rhabdomyolysis occur together, the clinical expression includes a combination of hemolysis-related symptoms and muscle breakdown symptoms:
1. Muscle Symptoms of Rhabdomyolysis:
• Severe Muscle Pain and Weakness: The hallmark of rhabdomyolysis is intense muscle pain, particularly in large muscle groups like the thighs, shoulders, or back. Muscle weakness may also develop.
• Dark, Tea-Colored Urine: Myoglobin, released from damaged muscles, can cause dark urine, which is also seen in G6PD deficiency due to hemolysis (causing hemoglobinuria).
• Fatigue and Malaise: Generalized weakness and exhaustion are common as muscle fibers break down and essential cellular functions are impaired.
2. Hemolysis Symptoms from G6PD Deficiency:
• Jaundice (Yellowing of Skin and Eyes): Hemolysis causes the release of bilirubin, leading to jaundice.
• Anemia: As red blood cells are destroyed, the individual may develop anemia, resulting in symptoms like shortness of breath, dizziness, and pallor.
• Tachycardia (Fast Heart Rate): The body compensates for anemia by increasing the heart rate, especially during or after exertion.
3. Laboratory Findings:
• Elevated Creatine Kinase (CK) Levels: CK is released from damaged muscles and is a key marker of rhabdomyolysis. In severe cases, CK levels can rise to 5,000 U/L or more.
• Hemoglobinuria/Myoglobinuria: The breakdown of red blood cells (hemoglobinuria) and muscle cells (myoglobinuria) can both cause dark urine, indicating damage from both hemolysis and rhabdomyolysis.
• Elevated Bilirubin: Due to hemolysis, there may be an increase in both direct and indirect bilirubin levels in the blood.
• Electrolyte Imbalances: Rhabdomyolysis can cause imbalances like hyperkalemia (high potassium), which can lead to life-threatening complications such as cardiac arrhythmias.
4. Potential Complications:
• Acute Kidney Injury (AKI): Myoglobin from rhabdomyolysis and hemoglobin from hemolysis can clog the kidneys, leading to AKI. This manifests as reduced urine output, swelling, and confusion.
• Cardiac Complications: Electrolyte disturbances (especially hyperkalemia) can lead to arrhythmias, including potentially fatal cardiac arrest.
• Disseminated Intravascular Coagulation (DIC): In severe cases, both hemolysis and rhabdomyolysis can trigger clotting disorders, leading to uncontrolled bleeding and clot formation throughout the body.
Triggers of Rhabdomyolysis in G6PD Deficiency:
• Infections: Bacterial and viral infections (e.g., pneumonia, influenza) are common triggers of oxidative stress, leading to both hemolysis and rhabdomyolysis.
• Medications: Certain drugs, like antimalarials (e.g., primaquine) or sulfa drugs, can cause oxidative stress, leading to hemolysis and muscle breakdown.
• Physical Exertion: Intense exercise, especially in hot or cold environments, can trigger both hemolysis and rhabdomyolysis in individuals with G6PD deficiency.
• Fever: Infections that induce fever can increase the metabolic demands on the body, leading to oxidative stress and muscle damage.
Conclusion:
In individuals with G6PD deficiency, rhabdomyolysis often presents alongside hemolysis, with overlapping symptoms such as muscle pain, fatigue, jaundice, and dark urine. The triggers—such as infections, oxidative medications, or physical exertion—can lead to oxidative stress that damages both red blood cells and muscle tissue, causing hemolysis and rhabdomyolysis. Prompt medical treatment is crucial to prevent complications such as kidney failure or cardiac arrest.
Many still are not aware of how serious this condition is.
Today | Closed |

Copyright © 2020-2024 Farron D. - All Rights Reserved.